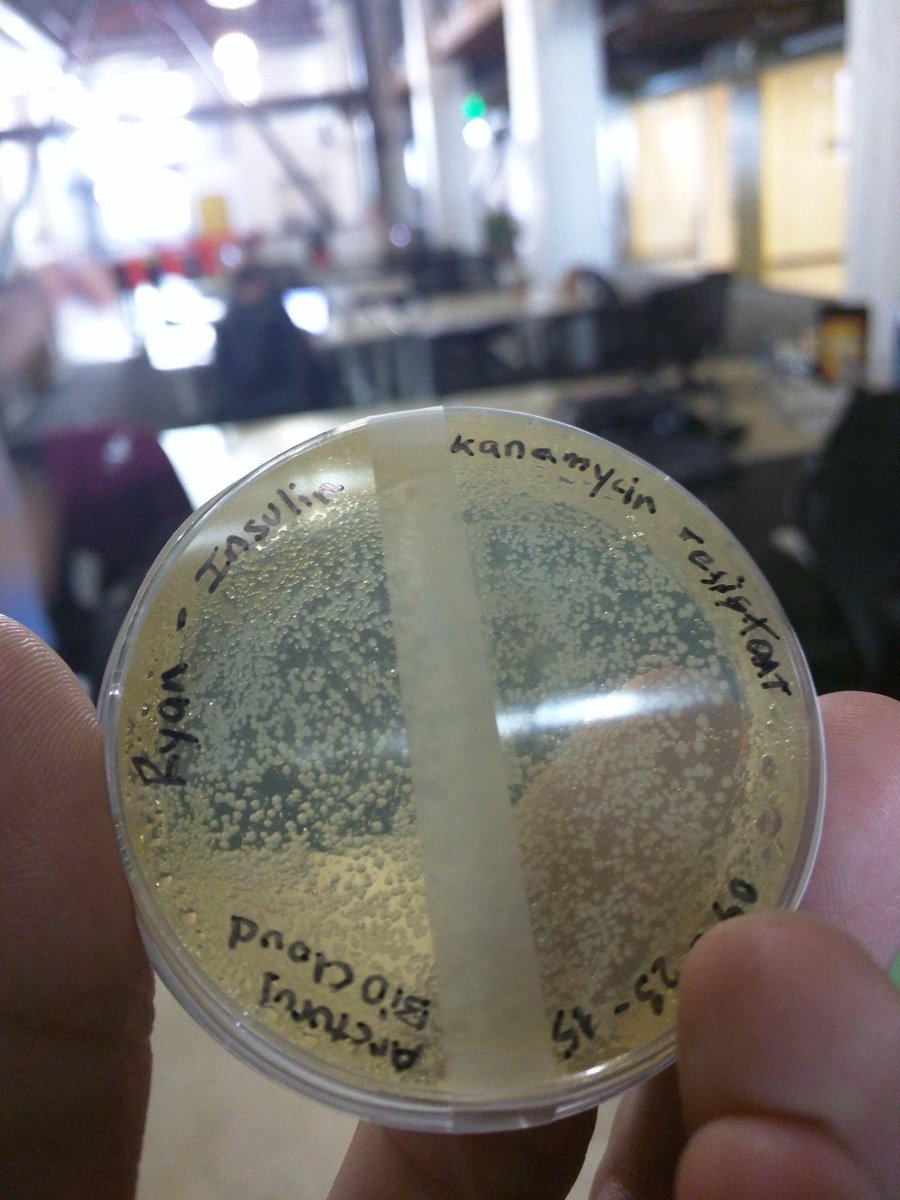
RyanBethencourt's tweet image. #OpenSource #Insulin has arrived! Thanks to @arcturusbio and the @CountrCultrLabs team! I'll bring it this week!

BioLoom
@Bio_Loom
We are making the next generation of performance BioFabrics.
You might like
@indbio Co-labs means more coLABoration. @arturoeliz founder of @ClaraFoods is checking out our raw materials.

#OpenSource #Insulin has arrived! Thanks to @arcturusbio and the @CountrCultrLabs team! I'll bring it this week!

The glamorous life of a CEO @valinanomedical @MYidiagnostics @KonikuTech @indbio #startup

.@Ginkgoo Bioworks Closes $45M Series B: synbiobeta.com/ginkgo-biowork… #synbio #biotech #syntheticbiology

The @indbio teams at #SolidCon #FutureofBiotech @arcturusbio @pembient @aBioBot @Bio_Loom @arvndgpta

.@Bio_Loom is making microbial hydrogels to accelerate wound healing for a lower cost #indiebio1 @jennykaehms

@Bio_Loom helping you to close your wounds faster using bacterial cellulose at @indbio #indiebio1

.@Bio_Loom's future plans include artificial skin and scaffolds for drug delivery #indiebio1

At #indiebio1 demo day. V. interesting biotech on display. Clara Foods has 1st round funding, BioLoom getting strong interest. V. Cool.
Watch @pembient @ClaraFoods @arcturusbio @RanomicsInc us @Bio_Loom @Orphidia_HQ @BlueTurtle_com @extembio @aBioBot buff.ly/1FIWqwG

New article up on Biotech Automation! Lots of exciting options out there for researchers.
The #Automation War: Cloud Labs vs. Desktop #Robots synbiobeta.com/the-automation… #robotics #labautomation #science #synbio


Prepping samples for @indbio demo day (t minus 8 days). Doesn't our material looks like decellularized skin?

@sbroderick @TextileWorks @RyanBethencourt @Bio_Loom @indbio Being the first human to have a band aid grown from bacteria, I'll let it slide
@worksonmypc DAMMIT JIM, I'M A TEXTILE SYNTHESIZER, NOT AN ADHESIVE SYNTHESIZER! @TextileWorks @RyanBethencourt @Bio_Loom @indbio
@TextileWorks @RyanBethencourt @Bio_Loom @indbio My superhealing bandaid was effective, but they need to work on the adhesive. :)
Benefits of being a mentor @indbio when you get a blister, you get a @Bio_Loom biobandage @worksonmypc




It's #vegan microbial cellulose. @RyanBethencourt of @indbio says it, "Tastes like Gummi Bears".

Peter Thiel: “It’s those who have an optimism about what can be done that will shape the future.” wapo.st/1Ifdy2e via @arianaeunjung
United States Trends
- 1. #SmackDown N/A
- 2. #DragRace N/A
- 3. #OPLive N/A
- 4. Dabo N/A
- 5. Pistons N/A
- 6. #WWE2K26 N/A
- 7. #ZuffaBoxing01 N/A
- 8. Briar N/A
- 9. Attitude Era N/A
- 10. Jen Z N/A
- 11. Hugo N/A
- 12. Antarctica N/A
- 13. Shinsuke N/A
- 14. Cade N/A
- 15. Jacob Fatu N/A
- 16. Jalen Green N/A
- 17. FEMA N/A
- 18. Jade Cargill N/A
- 19. Ron Holland N/A
- 20. Clemson N/A
Something went wrong.
Something went wrong.

























































































































